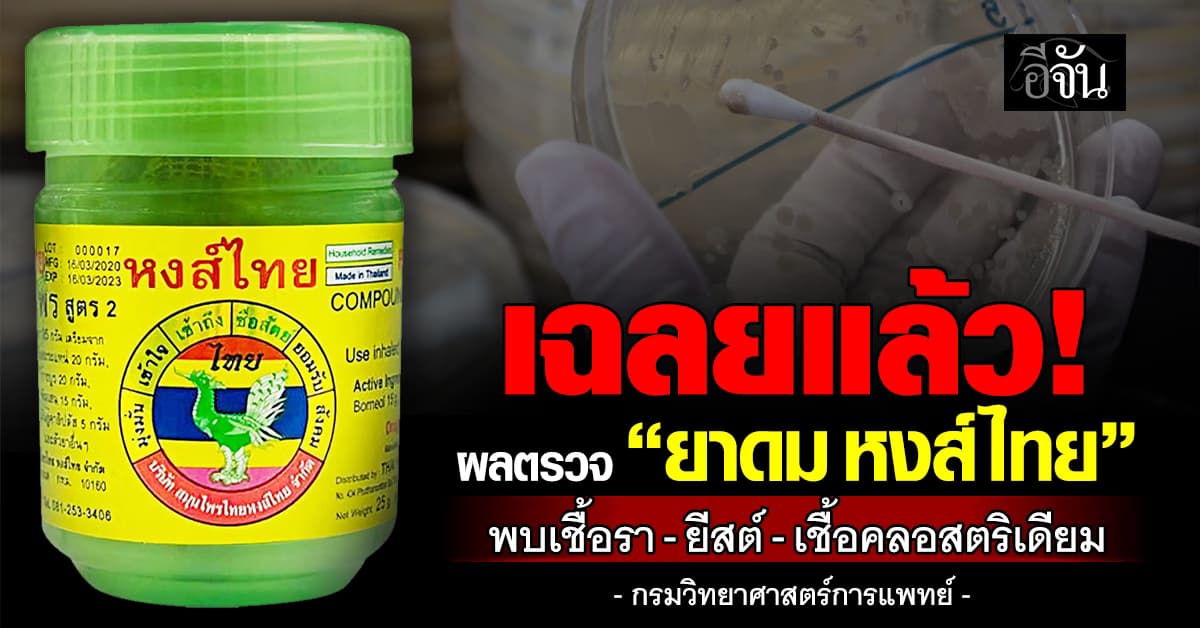
กรมวิทยาศาสตร์การแพทย์ เผย ผลตรวจ “ยาดมสมุนไพรหงส์ไทย” เเล้ว

กรมวิทยาศาสตร์การแพทย์ เผย ผลตรวจ “ยาดมสมุนไพรหงส์ไทย” เเล้ว
29 ตุลาคม 2568

29 ตุลาคม 2568

28 ตุลาคม 2568

27 ตุลาคม 2568

18 ตุลาคม 2568

17 ตุลาคม 2568

7 ตุลาคม 2568

3 ตุลาคม 2568

27 กันยายน 2568

25 กันยายน 2568

23 กันยายน 2568

22 กันยายน 2568
18 กันยายน 2568